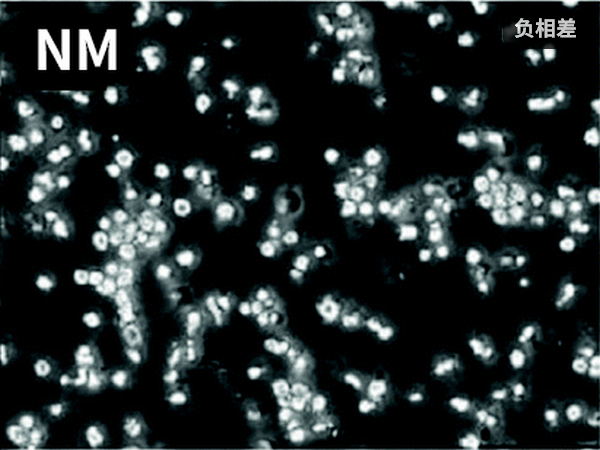

微信扫描二维码,点击右上角 ··· 按钮
转发给朋友或分享到朋友圈
倒置显微镜与相差显微镜有何区别?
发布时间:2024-12-06
访问量:453

倒置显微镜通常属于相差显微镜
倒置显微镜是一种结构型态,相差显微镜是一种功能划分,两者无法直接对比。

倒置显微镜配备相差环板来实现相差
倒置生物显微镜通常属于相差显微镜。倒置显微镜的透射光源在载物台上,物镜在载物台下,故称“倒置显微镜”。倒置生物显微镜的透射光源和物镜都是长工作距离设计,通常会配备推拉式相差环板和相差物镜,可实现相差观察功能,以便观察接近透明的未染色细胞等样品。

正置也能实现相差(升级荧光和相差后的CX43)
正置显微镜也可以实现相衬观察,只是相对少见。简易的正置相衬使用类似倒置的推拉式相差环板,搭配带插槽的聚光镜,由于尺寸更小,精密度要求更高,而且可能还会有漏光等问题,更可靠的设计是转盘式切换的聚光镜,这是很多专业品牌正置显微镜实现相衬切换的思路。

相差可以观察透明细胞样本
相差显微镜指能进行相差观察的显微镜,相差观察又称相衬观察、泽尼克相衬法观察,是一种利用相位差物理原理提升透明样品对比度的技术,主要用于未染色的细胞等样品,这些样品在明场下几乎是透明的,难以看清,而染色则会影响其活性因而不适用,通过相差观察,样品物质和厚度的差异将会转化成对比度,从而揭示明场观察无法看清的细节。
相差不适合看厚的和楔形的样品,升级DIC解决
相差观察的优点很明显,它可以不用染色就看清培养皿中的细胞和水中的微生物等样品,十分方便且实现成本低,局限在于不适合厚度大的样品,以及楔型结构的样品,这些样品可能需要用DIC微分干涉相衬或者HMC霍夫曼调制相衬来进行观察,前者具有非常好的立体感和极佳的细节表现能力,但成本极高,后者虽然会有色差问题,但能以显著更低的成本实现类似DIC的强立体感,适合批量部署,因此在IVF辅助生殖等领域会有应用。
除常规相差,还有特殊的负相差
相衬观察还有正负和对比度高低之分,常见的相衬是正相衬,背景是亮色的,样品被高亮光环包围。而负相衬背景呈暗色,类似暗场,样品主体会呈高亮。负相差物镜有高对比(NH)和中对比度(NM)区别,会标记在物镜上。

无限远倒置荧光显微镜合成图像
最后还有一点需要补充的是,固定筒长显微镜和无限远光学显微镜在相衬使用上的一个区别。在切换相衬和荧光观察方式时,需要把光学元件移入和移出光路,对于固定筒长显微镜来说,额外的光学元件移入后,需要做补偿以满足固定筒长需要,作为结果,不同观察方式会有一定的成像倍率差异,视野不是完全一致的。
无限远光学显微镜可以做到相衬成像视野和荧光成像视野完全一致,因此可以拍摄合成出有轮廓感/立体感的细胞荧光图像。一般这需要先用平场消色差相衬物镜拍摄相衬,然后切换到半复消色差物镜拍摄荧光,以免损失荧光亮度,为了方便用户进行这种拍摄,明美还推出了半复消色差相衬物镜,可以一个物镜把相衬和荧光都拍好。
免责声明
本站无法鉴别所上传图片、字体或文字内容的版权,如无意中侵犯了哪个权利人的知识产权,请来信或来电告之,本站将立即予以删除,谢谢。
微信扫描二维码,点击右上角 ··· 按钮
转发给朋友或分享到朋友圈